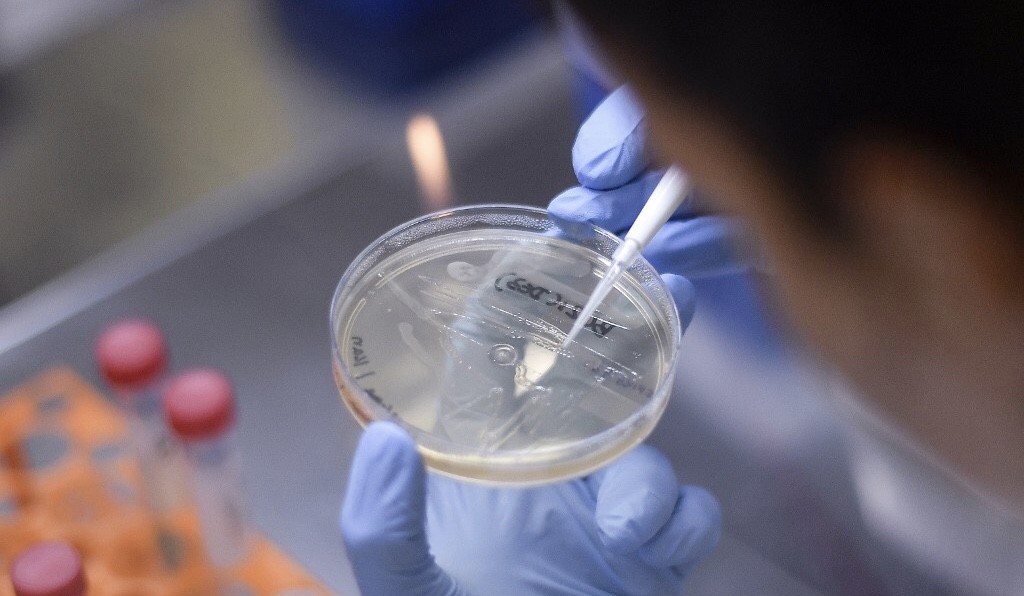
Hasil Uji Coba Vaksin Corona dari Oxford Menggembirakan, Mungkin Digunakan Tahun Ini

Hasil Uji Coba Vaksin Corona dari Oxford Menggembirakan, Mungkin Digunakan Tahun Ini

LONDON, iNews.id - Uji coba tahap awal vaksin virus corona yang dikembangkan AstraZeneca bersama Universitas Oxford Inggris menunjukkan hasil menggembirakan.
Dalam uji coba terhadap manusia, vaksin menghasilkan respons kekebalan terhadap virus, sebagaimana data yang dirilis Senin (20/7/2020). Uji coba ini memunculkan harapan besar bahwa vaksin bisa digunakan pada akhir tahun ini.

Disebut AZD1222, vaksin tersebut digambarkan oleh kepala ilmuwan Organisasi Kesehatan Dunia (WHO) sebagai kandidat utama dalam perlombaan menghentikan pandemi Covid-19 yang sejauh ini telah merenggut lebih dari 610.000 nyawa di seluruh dunia. Sejauh ini ada 150 vaksin yang dikmbangkan di seluruh dunia, termasuk oleh China dan Amerika Serikat.
Vaksin AstraZeneca dan Universitas Oxford ini juga tidak menimbulkan efek samping serius, demikian hasil uji coba yang diterbitkan dalam jurnal medis The Lancet. Respons lebih kuat ditunjukkan pada orang yang menerima dua dosis vaksin.
Dubes Rusia untuk Inggris Sebut Hacker Tak Mungkin Curi Data Penelitian Vaksin Corona
Perdana Menteri Inggris Boris Johnson memuji hasil uji coba tersebut dengan menyebutnya sebagai berita sangat positif, meskipun para peneliti mengingatkan proyek ini masih pada tahap awal.